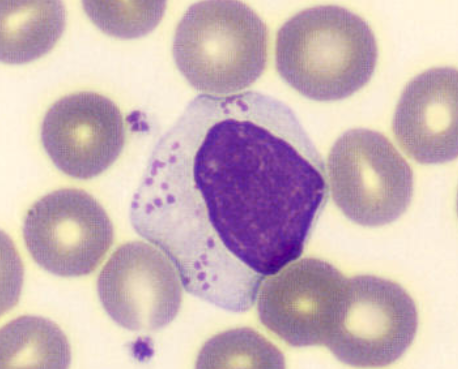

Leucemia de linfócitos grandes granulares
A leucemia de linfócitos grandes granulares é uma doença linfoproliferativa rara, caracterizada pela expansão clonal de linfócitos T maduros ou células natural killer. Apesar de sua baixa incidência, essa entidade apresenta relevância clínica devido à heterogeneidade de manifestações e à possibilidade de diagnóstico incidental em exames laboratoriais de rotina.
Além disso, a evolução clínica geralmente indolente pode retardar o reconhecimento da doença, especialmente em pacientes assintomáticos.
Aspectos fisiopatológicos e classificação da Leucemia de linfócitos grandes granulares
A leucemia de linfócitos grandes granulares compreende um espectro heterogêneo de distúrbios clonais, envolvendo predominantemente células T citotóxicas, que representam a maioria dos casos descritos. Esse subtipo apresenta comportamento crônico, com baixa taxa de progressão e curso clínico estável na maior parte dos pacientes.
Entretanto, variantes menos frequentes também são descritas, incluindo fenótipos atípicos, como a expressão de CD4 isolado ou associada a outros marcadores. Nesses casos, mecanismos fisiopatológicos distintos parecem estar envolvidos, incluindo associações com infecções virais e alterações moleculares específicas.
Manifestações clínicas e achados laboratoriais na Leucemia de linfócitos grandes granulares
Do ponto de vista clínico, muitos pacientes com leucemia de linfócitos grandes granulares permanecem assintomáticos por longos períodos, sem alterações significativas ao exame físico. A ausência de citopenias importantes, visceromegalias ou fenômenos autoimunes é frequentemente observada, especialmente nos subtipos atípicos.
Nos exames laboratoriais, o achado mais comum é a linfocitose persistente, identificada de forma incidental em hemogramas de rotina. Assim, a correlação entre dados clínicos e laboratoriais é fundamental para evitar diagnósticos equivocados ou atrasos na investigação especializada.
Conduta clínica e acompanhamento na Leucemia de linfócitos grandes granulares
A abordagem terapêutica da leucemia de linfócitos grandes granulares é individualizada e baseada no quadro clínico e na presença de critérios para tratamento. Em pacientes assintomáticos, a conduta mais adotada é o acompanhamento clínico regular, permitindo a detecção precoce de alterações clínicas ou laboratoriais e a introdução oportuna da terapêutica, quando necessária, evitando intervenções desnecessárias.
Conclusão
A leucemia de linfócitos grandes granulares é uma entidade rara, de comportamento predominantemente indolente, cujo diagnóstico exige alto grau de suspeição e avaliação laboratorial especializada. O reconhecimento de fenótipos atípicos amplia a compreensão sobre a diversidade biológica dessa doença.
Assim, a atuação integrada entre laboratório e clínica é fundamental para o diagnóstico preciso, o acompanhamento adequado e a tomada de decisão terapêutica individualizada, contribuindo para melhor prognóstico e qualidade de vida dos pacientes.
O próximo passo de todo analista que deseja ter mais segurança na bancada
Todo analista que busca se destacar e se tornar um profissional mais atualizado, capacitado e qualificado para o mercado de trabalho precisa considerar uma pós-graduação.
Um profissional com especialização é valorizado na área laboratorial; esse é um fato inegável.
Unimos o útil ao agradável ao desenvolver uma pós-graduação em Hematologia Laboratorial e Clínica.
Para aqueles que procuram a comodidade de uma pós-graduação 100% online e ao vivo, sem abrir mão da excelência no ensino, temos a solução ideal.
Nossa metodologia combina teoria e prática da rotina laboratorial, garantindo um aprendizado efetivo.
Contamos com um corpo docente altamente qualificado, com os melhores professores do Brasil, referências em suas áreas de atuação.
No Instituto Nacional de Medicina Laboratorial, temos apenas um objetivo: mais do que ensinar, vamos tornar VOCÊ uma referência.
Toque no botão abaixo e conheça a pós-graduação em Hematologia Laboratorial e Clínica.
QUERO CONHECER TODOS OS DETALHES DA PÓS-GRADUAÇÃO
Referências:
FACCIN, J. C.; MIRANDA, C. C.; BARBOSA, I. S.; EDIR, A. C. B.; CECCHETTI, G.; ROMANO, R.; MODESTO, M. R.; AZAMBUJA, A. P.; ROSENDO, G. M. O.; BORGES, L. M. C. Leucemia de linfócitos grandes granulares de fenótipo atípico: um relato de caso. Hematology, Transfusion and Cell Therapy, v. 46, supl. 4, p. S1–S1267, 2024.
TERRA, B.; MAIA, A. M. Leucemia de grandes linfócitos granulares. Revista Brasileira de Hematologia e Hemoterapia, v. 32, n. 2, p. 141–148, 2010.
CONDORI, L.; MANCIOLA, F. L.; RIVA, M. E. Leucemia de linfócitos grandes granulares de células NK: reporte de caso. Ateneo Hematología, v. 29, n. 2, p. 72–76, maio/ago. 2025.



